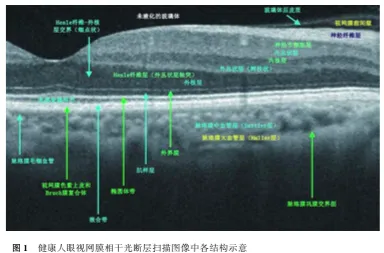

OCT 是 20 世纪 90 年代初期发展起来的一种新型非接 触、无创性的光学影像诊断技术,可对眼组织进行快速、实时 且高分辨率的断层成像,直观而清晰地显示活体视网膜及其 深层组织的细微结构,几乎达到活体解剖的效果。 并且,现代 OCT 还具备了单次随访功能,不同时间点对同一只眼进 行扫描时,选择Follow-up模式就能实现对同一扫描线的精 确对位,目前已成为眼科临床的一种基本的眼底影像诊断 和随访工具,正确判读 OCT 图像也成了眼科医生必须熟练 掌握的一项技能。
随着技术的进一步发展,OCT 图像的分辨率日趋增加, 所提供的信息也更为丰富而精细,且随着 EDI(enhanced depth imaging, EDI)技术的应用,其扫描深度也由原先的视 网膜到达脉络膜甚至巩膜,并能准确测量视网膜、脉络膜以及相应处病变的大小和厚度,无疑增加了眼科医生阅读 OCT 图像的难度,本文将就眼后节OCT 图像的解读方法与技巧进行简要介绍。
一、正常视网膜各层的OCT特征
判读 OCT 图像,首先应认清两个标 志性的组织成像的光学界面,即:
(1) 后玻璃体皮质与视网膜内界膜所形成的光 学界面,在 OCT 上,此界面上方无反射或 低反射区为玻璃体腔,下方即为视网膜 所在反射带;
(2) 视网膜神经上皮层与 RPE 之间所形成的光学界面, 在 OCT 上, 视网膜色素上皮层与 Bruch 膜的反射光 带互相重合无法分辨,表现为均质的高 反射条带,其下反射高低不一呈云雾状 的即为脉络膜组织的光带。上述两个光 学界面之间即为视网膜神经上皮层,在 OCT 上表现为层状排列的反射高低不一 的条带。
其次则需对视网膜神经上皮层的各亚层进行定位。
定位的诀窍在于—寻 找高反射条带。
对于外层视网膜而言, RPE 条带上方仍存在着三个高反射条带(图 2),自下而上分别对应嵌合带、椭圆体带和外界膜。
嵌合带,为 RPE 上方的 犬牙交错带,在解剖学上,为 RPE 细胞顶部长的微绒毛卷绕 包裹在光感受器外节的尖端;椭圆体带,即原先大家普遍称 作的 IS /OS 层,认为其是光感受器细胞内外节段的交界面, 但后来研究认为,此条带对应着光感受器内节的“椭圆体带”;再往上稍高信号即为外界膜。
而后根据层间反射 强弱的不同,自下而上依次为外核层、外丛状层、内核层、内 丛状层、神经节细胞层、神经纤维层。
由于视网膜血管位于 视网膜神经上皮层,因此在 OCT 上可见到位于视网膜神经 上皮内层的视网膜血管的特征性横切面影像,表现为多个直 径不一的中等反射的圆环,圆环内为高反射,其后信号衰减。
内界膜一般为与神经纤维层相重合的条带,无单独的影像结 构,但若视网膜前膜增生,则该反射可增强。

黄斑中心凹为视网膜最薄弱处,此处因无视网膜内层, 在 OCT 图像上可见视网膜内核层和内丛状层终止于中心凹 旁,中心凹处表现为一个圆滑的凹陷,光感受器细胞层明显 增厚,IS /OS 层可呈堆样突起。
二、视网膜各层病变的 OCT 图像特征
视网膜病变在 OCT 上的表现多种多样,归纳而言,反射 光带大体有以下几种改变:
-
形态改变:表现为原本平滑、均质的反射光带变得不 规则如锯齿状、树突状,或局部凹陷、突起等,如玻璃膜疣导 致的 RPE 的局部突起。
-
连续性及完整性的改变:表现为视网膜组织反射光 带的一层或多层不连续,出现裂隙、破裂、错位或缺损等,如 视网膜裂孔,在 OCT 上即表现为视网膜神经上皮层全层的 断裂、缺损,如脉络膜新生血管经典型 OCT 上即可出现 RPE 光带的隆起、破裂。
-
厚度改变:OCT 能准确测量视网膜、脉络膜的厚度, 因此能较为敏感地反映各组织的厚度改变。 根据厚度改变 的性质,可分为增厚和变薄两种类型,而根据出现厚度改变 的组织的范围,又可分为弥漫性和局限性,如,视网膜中央动 脉阻塞所致的视网膜水肿,在 OCT 上则表现为视网膜组织 反射光带的弥漫性增厚。 目前的 OCT 能精确测量视网膜各 层的厚度,从而观察其厚度的改变情况,如视网膜神经纤维 层厚度、神经节细胞-内丛状层复合体厚度、视网膜光感受器 细胞外节段的长度等,对为青光眼、视网膜退行性及变性性疾病的诊断及随访观察提供定量依据。
-
反射性:OCT获取图像的物理学基础是基于不同组 织之间存在着光学反射的差异性,病变位于视网膜或脉络 膜,均可引起相应部位及其后组织反射性质的改变。 根据其 对光反向散射的强度,病变可分为高反射和低反射两种类 型。 表现为高反射的病变有:大的硬性渗出、出血、色素性病 变、纤维化瘢痕、新生血管团、出血性神经上皮脱离或色素上 皮脱离、有髓神经纤维、牵拉条索、视网膜前膜等;表现为低 反射的病变有:视网膜水肿、黄斑囊样水肿、浆液性神经上皮 脱离或色素上皮脱离、视网膜劈裂形成组织间空腔等。 同 时,由于光的入射和来自深部组织的反射在被检出之前,必 须通过表层的组织,所有组织内部结构的反射都会受其上方 组织结构的影响,如视网膜神经上皮层萎缩时,其透光性增 强,则 RPE 的反射可明显增强。
原文节选自:中华眼科杂志 2014 年 6 月第 50 卷第 6 期